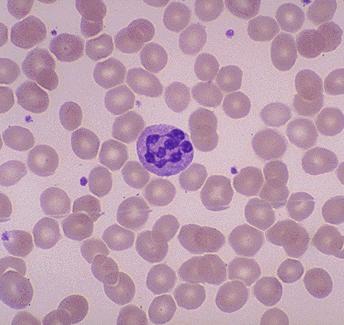

اهميتهما :
1- عملية تصنيع الدم 🩸
2- وظيفه عصبيه ونفسيه في حال فيتامين (ب١٢) وبدرجه اقل جدا (الفوليت)
1- عملية تصنيع الدم 🩸
2- وظيفه عصبيه ونفسيه في حال فيتامين (ب١٢) وبدرجه اقل جدا (الفوليت)
اسباب نقص ب١٢ :
١- عمليات قص وتحوير المعده
٢- الانيميا الخبيثه ذاتيه المناعه
٣- الاشخاص الذين يتبعون نظام غذائي مقتصر على النبات فقط
٤- سوء الامتصاص في الامعاء لوجود نوع من الديدان او مشاكل في البانكرياس وغيرها الكثير
١- عمليات قص وتحوير المعده
٢- الانيميا الخبيثه ذاتيه المناعه
٣- الاشخاص الذين يتبعون نظام غذائي مقتصر على النبات فقط
٤- سوء الامتصاص في الامعاء لوجود نوع من الديدان او مشاكل في البانكرياس وغيرها الكثير
٥- بعض الادويه مثل المتفورمين والنيتروس اوكسايد وادوية المعده
اسباب نقص الفوليت :
1-زيادة الاحتياج في حال الحمل والارضاع
٢-بعض الادويه كأدوية الصرع وبعض المضادات الحيويه والادويه المناعيه
٣- سوء الامتصاص
4-مرضى الغسيل الكلوي
1-زيادة الاحتياج في حال الحمل والارضاع
٢-بعض الادويه كأدوية الصرع وبعض المضادات الحيويه والادويه المناعيه
٣- سوء الامتصاص
4-مرضى الغسيل الكلوي
٥- تحلل في الدم مزمن وغيره الكثير
اعراضهما :
تعب وارهاق مرتبط بفقر الدم
مشاكل نفسيه وعصبيه وتكون في الغالب مع نقص فيتامين ب١٢ ويحدث تخدر وتنمل متساوي في الاطراف
وربما مشاكل في المشي او طريقة المشي وحتى شلل وعدم تحكم بالبول والبراز وغيرها الكثير
تعب وارهاق مرتبط بفقر الدم
مشاكل نفسيه وعصبيه وتكون في الغالب مع نقص فيتامين ب١٢ ويحدث تخدر وتنمل متساوي في الاطراف
وربما مشاكل في المشي او طريقة المشي وحتى شلل وعدم تحكم بالبول والبراز وغيرها الكثير
التشخيص :
1-فحص دم للهيموقلوبين ونرى ايضا متوسط حجم الكريات الحمراء بحيث تتضخم هذه الكريات قد يوجد هذا في امراض اخرى
2- شريحة الدم بحيث تظهر خلية النيوتروفيل متجزئه بشكل كبير
٢-فحص مستوى هذين الفيتامينين في الدم
1-فحص دم للهيموقلوبين ونرى ايضا متوسط حجم الكريات الحمراء بحيث تتضخم هذه الكريات قد يوجد هذا في امراض اخرى
2- شريحة الدم بحيث تظهر خلية النيوتروفيل متجزئه بشكل كبير
٢-فحص مستوى هذين الفيتامينين في الدم
٣- فحصان اكثر دقه في حال كان مستوى الفيتامينين في الدم قريبين من الطبيعي او طبيعي
وهما MMA and homocysteine ويعتبران فحصين تأكيديين
وهما MMA and homocysteine ويعتبران فحصين تأكيديين
العلاج :
هنالك مستحضرات كثيره
منها الحبوب او تحت اللسان والحقن عن طريق العضل او تحت الجلد واختياره يعتمد على خطورة الاعراض والقدره على الامتصاص
ودائما وابدا البحث عن اسباب هذا النقص ايضا عن طريق التاريخ المرضي .
هنالك مستحضرات كثيره
منها الحبوب او تحت اللسان والحقن عن طريق العضل او تحت الجلد واختياره يعتمد على خطورة الاعراض والقدره على الامتصاص
ودائما وابدا البحث عن اسباب هذا النقص ايضا عن طريق التاريخ المرضي .
ويجب ان نعلم ان البعض يظن ان اي تنمل قد يكون بسبب نقص هذا الفيتامين وهذا غير صحيح بل قد تكون المشكله مثلا في الاعصاب فلذلك يجب ان يذهب المريض للطبيب المختص حتى يتم تقييم الامور بدقه او قد تكون هذه الاعراض بسبب نقص النحاس مثلا في الدم
توجد هناك فحوصات اخرى قد يستخدمها الطبيب المختص في امراض الدم او غيرها عند الحاجه ولم اذكرها لسعة الموضوع والتفاصيل وهنالك عدة امور وكما اقول دائما وابدا يجب ان يكون التشخيص في المستشفى عند الطبيب المختص لانه هنالك امراض كثيره قد نضعها في الحسبان وتكون متشابهة في بعض الامور
للسائلين عن النسب المثاليه لهذي الفيتامينين
يعتمد على الوحده في حال فيتامين ب١٢ النسبه المثاليه تكون اكثر من ٣٠٠ بيكوقرام لكل ملي
اما الفوليت اكثر من ٤ نانوقرام لكل ملي
تختلف النسب بحسب وحدات القياس في المختبرات
يعتمد على الوحده في حال فيتامين ب١٢ النسبه المثاليه تكون اكثر من ٣٠٠ بيكوقرام لكل ملي
اما الفوليت اكثر من ٤ نانوقرام لكل ملي
تختلف النسب بحسب وحدات القياس في المختبرات
جاري تحميل الاقتراحات...